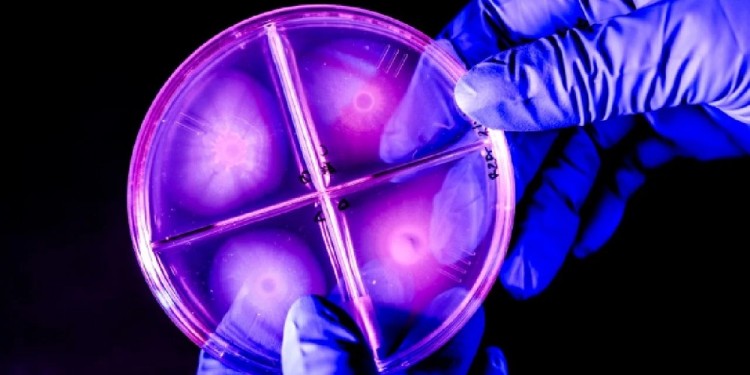
Fotos: Northeastern University

La investigadora Verónica Godoy-Carter, profesora asociada de biología y bioquímica en la Universidad Northeastern de Estados Unidos, ha logrado secuenciar el genoma de una bacteria descubierta en una excursión a la Patagonia chilena.
Las “rocas vivas” son biopelículas bacterianas, una capa de bacterias de sólo unas pocas células de espesor, descritas por la investigadora como “pequeñas montañas de biopelículas gigantes se han acumulado y calcificado en formas que parecen rocas, llamadas estromatolitos, y tienen miles de millones de años”.
“Son anteriores a los humanos, a nuestros ancestros primates, tal vez incluso a la propia vida multicelular”, reveló.

Godoy-Carter ha logrado secuenciar el genoma de una de estas colonias bacterianas, una especie dentro de un género llamado Janthinobacterium, que se encuentra en el suelo y el agua, sobrevive a pesar de estar sometido a temperaturas gélidas y tiene un color violeta distintivo.
La Janthinobacterium crea comunidades multicelulares increíblemente robustas. “Se cree que este tipo de formaciones creadas por bacterias son, en gran medida, las primeras células vivas, organizadas, de la Tierra”, contó la científica.
El entusiasmo de Godoy-Carter es contagioso: “Las bacterias son los organismos más asombrosos de la Tierra. Pueden vivir sin nosotros, pero nosotros no podemos vivir sin ellas”.
Bacteria violeta brillante
En 2018, Godoy-Carter dirigió a un grupo de estudiantes e investigadores en un viaje “Diálogo de Civilizaciones” a la Patagonia, donde visitaron estas “rocas vivientes” y fueron a cazar bacterias únicas.
La investigación se centró en cómo las bacterias se adaptan a los cambios en su entorno, especialmente su respuesta al daño del ADN y las mutaciones que pueden ocurrir (o no) en respuesta a ese daño.

Lo que encontraron fue una bacteria de colores brillantes cuyo biofilm era lo suficientemente fuerte como para actuar como una tapa sobre un tubo de ensayo, reteniendo el líquido en su interior.
Aunque su trabajo todavía está en las primeras etapas, Godoy-Carter afirma entusiasmada que “con las biopelículas, podemos fabricar nuevos plásticos, nuevos textiles, tal vez podamos fabricar los textiles con el pigmento y es probable que el pigmento ayude a la bacteria a protegerse contra la radiación ultravioleta del sol”.
El trabajo recién comienza
Las bacterias extraídas de entornos externos son muy difíciles de trabajar, porque tienen sus propios sistemas y no son familiares para el laboratorio. Tienden a cambiar, a apagarse. Sin embargo, ahora que Godoy-Carter y su equipo han secuenciado el genoma de Janthinobacterium, podrán aislar los genes particulares que más les interesa estudiar y podrán conectar eficazmente esos genes a otras bacterias más amigables para el laboratorio.
Los biólogos de sistemas denominan a estas bacterias hospedadoras chasis, como el chasis de un auto al que se pueden montar otras piezas. “Necesitamos encontrar un buen chasis”, afirma Godoy-Carter. “Y creo que ya lo tenemos”.

Godoy-Carter dice que todo el equipo de su expedición estaba entusiasmado con el descubrimiento y lo que encontraron en el laboratorio. Los mismos investigadores universitarios (y otros que la acompañaron a la Patagonia) trabajaron con Janthinobacterium en Estados Unidos.
Fuente: Meteored